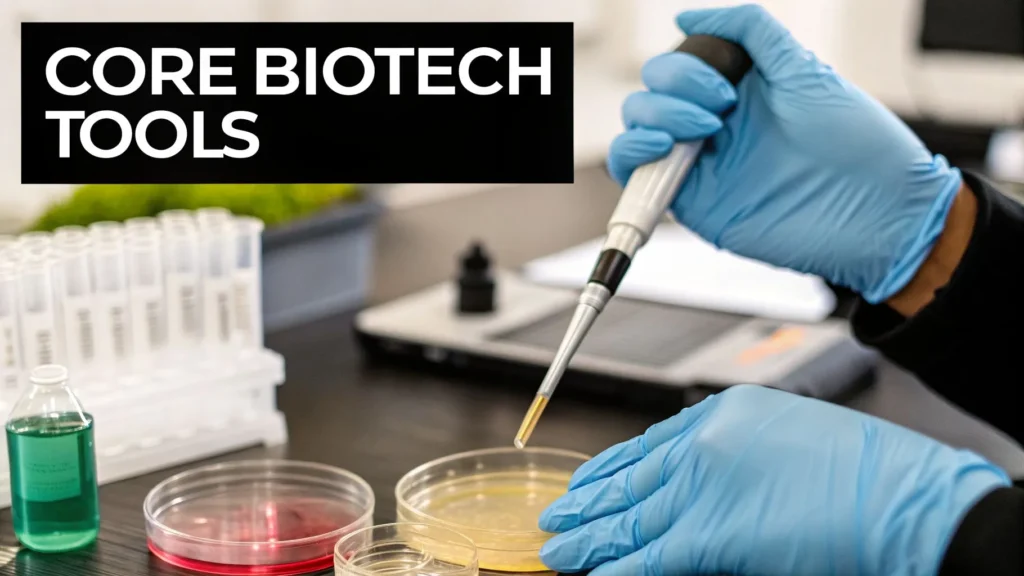
Scientist using pipette in lab with petri dishes and test tubes, illustrating core biotechnology tools.

When you hear the term biotechnology, it’s easy to picture scientists in sterile labs working on futuristic cures. While that’s part of the story, the reality is much broader and surprisingly familiar.
At its core, biotechnology is the science of using living organisms—or their parts, like cells and bacteria—to create products or solve problems. Think of it as a biological toolkit. For millennia, we used this kit without even knowing it to brew beer and bake bread. Today, we’re just applying it on a much more precise, molecular level.
What Is Biotechnology In Simple Terms
So, what does that mean in practice? Think of it like a new kind of engineering. Instead of using steel and concrete to build a bridge, biotech scientists use the building blocks of life: cells, genes, and proteins. This allows them to design everything from life-saving medicines to crops that can survive a drought.
It’s all built on a powerful idea: biology itself can be a form of technology. We can guide natural processes to work for us in very specific ways. This isn’t just a sci-fi concept; it’s a science that’s already woven into our daily lives, often in ways you might not even notice.
The main principle is to harness the power of living systems to tackle challenges in health, agriculture, and industry. It’s about working with nature to create solutions it might not have come up with on its own.
Before we dive deeper, here is a quick overview of biotechnology’s core components and what it aims to achieve.
Biotechnology At A Glance
| Component | Description | Simple Example |
|---|---|---|
| Living Organisms | Using whole organisms like bacteria, yeast, or plants. | Using yeast to make bread rise. |
| Biological Molecules | Working with parts of organisms, like DNA, RNA, or proteins. | Using enzymes in laundry detergent to break down stains. |
| Processes | Guiding or modifying biological processes for a specific outcome. | Fermenting grapes to make wine. |
| Products | The end result, which can be a new drug, a hardier plant, or a biofuel. | Creating insulin for diabetics using engineered bacteria. |
This table shows how the same fundamental idea—using life to create something new—applies across different scales, from a single molecule to an entire organism.
Biotechnology From Past to Present
The roots of biotechnology go back thousands of years. Long before we had a name for it, civilizations were practicing it.
- Ancient Applications: When our ancestors used yeast to leaven bread or fermented milk to create yogurt, they were using microorganisms to transform one thing into another. This was the dawn of biotechnology.
- Modern Advancements: Today, we’ve moved from using whole organisms to manipulating their genetic blueprints. Scientists can now edit DNA with incredible precision, program bacteria to produce human insulin, and design enzymes that can break down industrial waste.
This journey from ancient craft to modern science highlights just how versatile the field is. The same basic principles that gave us cheese are now fueling the development of cutting-edge cancer therapies.
The Scale of Modern Biotechnology
Modern biotechnology isn’t just a scientific marvel; it’s an economic powerhouse. It has become a huge driver of the global economy, pushing innovation in multiple sectors. For instance, the global biotechnology market is on track to hit an estimated USD 1.77 trillion in 2025 and is expected to soar to an incredible USD 6.34 trillion by 2035.
If you’re interested in the numbers, you can find a complete breakdown by checking out the full biotechnology market report from Precedence Research. This explosive growth shows just how valuable this science has become in solving some of the world’s most complex problems.
The Four Colors Of Biotechnology Explained
Biotechnology is a massive field, touching almost everything in our lives. To get a handle on it, experts have come up with a handy color-coding system. Think of it like sorting a massive toolbox—each color helps you quickly find the right tool for a specific job.
This system breaks down the science into four main branches: Red, Green, White, and Blue. Understanding what each color represents is the key to seeing how biotechnology is tackling some of the world’s biggest challenges.
Red Biotechnology: Medical Applications
Red Biotechnology is probably the one you’ve heard the most about. It’s all about human health and medicine. This is where scientists use biological systems to diagnose, treat, and prevent diseases. We’ve moved far beyond simple chemical pills; now, we’re creating treatments from living organisms themselves.
A few key applications of Red Biotechnology include:
- Vaccine Development: Using bits of genetic code from a virus or bacterium to teach our immune system how to fight it off.
- Gene Therapy: Going straight to the source by fixing or replacing defective genes that cause disorders like cystic fibrosis or sickle cell anemia.
- Personalized Medicine: Designing treatments based on a person’s unique genetic profile. This is a game-changer in cancer therapy, making drugs more effective with fewer side effects.
- Biopharmaceuticals: Turning microbes like bacteria and yeast into tiny factories that produce life-saving proteins, such as insulin for diabetics or monoclonal antibodies for autoimmune diseases.
At its core, Red Biotechnology is about working with biology to heal us, leading to more precise and powerful treatments than ever before.
Green Biotechnology: Agricultural Innovation
Next up is Green Biotechnology, which shifts the focus to farms and food. The main goal here is straightforward: grow more resilient, nutritious, and sustainable crops to feed a booming global population, all while lightening agriculture’s environmental footprint.
This is all about improving plants from the inside out.

The impact is already huge. Biotech crops are grown on 190 million hectares worldwide, and the results speak for themselves. Studies show they have increased farm yields by an average of 22% while cutting the use of chemical pesticides by 37%. You can dig deeper into these numbers with these insights into the biotechnology market.
This isn’t just theory; it’s a proven way to make our food supply more productive and kinder to the planet.
Key Takeaway: Green Biotechnology isn’t about creating sci-fi “super crops.” It’s about building smarter agricultural systems that can handle real-world problems like drought, pests, and poor soil to keep our food supply secure.
White Biotechnology: Industrial Processes
While Red and Green biotech handle our health and food, White Biotechnology takes on the industrial world. Also called industrial biotech, its mission is to make manufacturing cleaner, more efficient, and sustainable by swapping out polluting chemical processes for bio-based ones.
Imagine microorganisms like bacteria and fungi as microscopic, programmable factories. Scientists can tweak their biology to produce an incredible range of useful things.
Here are some of the biggest applications:
- Biofuels: Using fermentation to turn crops like corn and algae into ethanol and biodiesel, offering a renewable alternative to fossil fuels.
- Bioplastics: Programming microbes to make biodegradable plastics from plant materials, tackling the global plastic pollution crisis head-on.
- Enzymes: Creating highly specific enzymes for everyday products, from laundry detergents that work in cold water to food ingredients that improve texture and shelf life.
By tapping into nature’s own chemistry, White Biotechnology helps industries slash waste, save energy, and reduce their environmental impact.
Blue Biotechnology: Marine Discoveries
Finally, we have Blue Biotechnology, which dives into the vast, mysterious world of marine and aquatic organisms. Our oceans are home to an incredible diversity of life, much of it adapted to extreme conditions. These creatures hold unique biological secrets that have a ton of potential.
Blue Biotechnology is one of the newer fields, but the promise is immense. Researchers are exploring everything from the deepest oceans to local lakes for new breakthroughs.
Current areas of focus include:
- New Drugs: Finding novel compounds in marine sponges, corals, and bacteria that can be developed into powerful new antibiotics and cancer treatments.
- Aquaculture: Improving the health, disease resistance, and growth of farmed fish to make seafood production more sustainable.
- Biomaterials: Studying the amazing properties of marine life—like the super-strong glue mussels use to stick to rocks—to inspire new materials for medicine and industry.
This branch is a powerful reminder that some of the best solutions to our problems might be hiding in plain sight, deep beneath the waves.
To wrap it all up, let’s look at how these four branches compare side-by-side. Each has a distinct purpose, but they all share the same core idea: using biology to build a better world.
Comparing The Branches Of Biotechnology
| Branch (Color) | Primary Goal | Key Application Example |
|---|---|---|
| Red | Improve human health and medicine | Developing personalized cancer treatments based on a patient’s DNA. |
| Green | Enhance agriculture and food production | Engineering drought-resistant corn to ensure stable crop yields. |
| White | Create sustainable industrial processes | Using microbes to produce biodegradable plastics from plant starches. |
| Blue | Utilize marine and aquatic resources | Discovering new antibiotic compounds from deep-sea sponges. |
As you can see, the “colors” provide a simple but effective way to map out this complex scientific landscape, from the doctor’s office to the factory floor and beyond.
Unpacking The Core Techniques Of Modern Biotech
To really get what biotechnology is all about, you have to look inside the scientist’s toolkit. While the applications seem endless, they’re all built on a handful of foundational methods. These are the engines that power discovery, letting us tell living systems what to do.
These techniques range from classic biological processes that we’ve fine-tuned for industry to incredible breakthroughs that have completely redefined what’s possible in the lab. Let’s break down four of the most important ones.
Genetic Engineering: The Original Cut-And-Paste
At its core, genetic engineering is the art of manually adding a piece of new DNA into an organism. The best way to think of it is as a biological “cut and paste.” Scientists can snip a desirable gene from one organism and slot it into the DNA of another.
This is exactly how the first batches of synthetic human insulin were made back in the 1970s. Researchers took the human gene for producing insulin and inserted it into common bacteria. The bacteria, now carrying new instructions, started churning out human insulin that could be purified for people with diabetes.
This method is the foundation for transferring specific traits, like giving a plant built-in pest resistance or programming a microbe to produce a medical protein. It’s the technique that really opened the door for modern biotech.
CRISPR: A “Find And Replace” For DNA
If genetic engineering is “cut and paste,” then CRISPR is the “find and replace” tool. Known officially as CRISPR-Cas9, this technique lets scientists edit an organism’s existing DNA with surgical precision. It can hunt down a specific genetic sequence, snip it out, and swap in a corrected version.
Think of it like finding a single typo in a thousand-page book. Older methods might have required you to rip out the whole page, but CRISPR lets you find that exact word and fix it without touching anything else.
This pinpoint accuracy has made it a game-changer for medical research. Scientists are actively exploring how to use it to fix the genetic errors behind inherited diseases like sickle cell anemia and Huntington’s disease, offering real hope for one-time, permanent cures.
Fermentation: Miniature Factories At Work
Fermentation might be one of the oldest tricks in the biotech book, but it’s still a cornerstone of the industry today. It harnesses microorganisms—like yeast, bacteria, or algae—and puts them to work as tiny, self-replicating factories. By feeding these microbes a specific diet in a controlled environment (called a bioreactor), we can get them to produce all sorts of valuable compounds.
You’d be surprised how many everyday products rely on this process:
- Biofuels: Fermenting corn or sugarcane to create ethanol.
- Food Products: Making everything from yogurt and cheese to some plant-based meats.
- Biopharmaceuticals: Manufacturing complex medicines, enzymes, and vaccines.
The modern spin on this, often called precision fermentation, gives us even more control. Scientists can now engineer microbes to produce very specific, high-value proteins that would be nearly impossible to create any other way.
Cell Culture: Growing Life In The Lab
Finally, we have cell culture. This is the technique of growing cells—human, animal, or plant—outside of their original body in a controlled lab setting. The cells are kept alive and happy in dishes or flasks filled with a nutrient-rich liquid.
This method is absolutely essential. For one, it allows researchers to test how cells react to new drugs or diseases without having to test on a whole living thing. If you’re curious about how we handle the massive amounts of data from these experiments, our guide on what is bioinformatics dives into the computational side of things.
Cell culture is also the technology behind cutting-edge cell-based therapies, where healthy cells are grown in a lab and then introduced into a patient to heal damaged tissues. It’s even the science that makes lab-grown meat and other cellular agriculture products possible.
How Biotechnology Is Revolutionizing Modern Medicine
If there’s one area where biotechnology is making its most dramatic impact, it’s in healthcare. This field, often called Red Biotechnology, taps into the very building blocks of life to completely change how we find, fight, and even fix diseases. It’s moving us away from a one-size-fits-all approach toward something far more personal and powerful.

The numbers tell the story. Healthcare is the undisputed engine of the biotech industry, set to command a massive 51% market share in 2025. A core technique, DNA sequencing, made up 17.53% of the market that same year, driving everything from early disease screening to faster drug development. You can dive deeper into these figures and what they mean by exploring the global biotechnology market’s projected growth.
All this investment is paying off with real-world breakthroughs that are changing people’s lives every single day.
The Rise Of Personalized Medicine
For a long time, medicine was a game of averages. A doctor would prescribe a standard drug for a given condition and hope for the best. Personalized medicine flips that script completely by asking a simple but profound question: what makes you, you?
By digging into a patient’s unique genetic code, lifestyle, and even environment, doctors can now predict which treatments will be most effective for that specific person. It’s like getting a biological roadmap made just for you.
This has been a game-changer in cancer treatment. Instead of treating all lung cancers identically, oncologists can now pinpoint the exact genetic mutation fueling a tumor and prescribe a drug designed to attack that specific vulnerability.
Biopharmaceuticals Targeted Therapies
That brings us to one of Red Biotechnology’s biggest wins: biopharmaceuticals. Unlike old-school chemical drugs, these are medicines created from living sources, like specially engineered cells or bacteria. The most famous of these are monoclonal antibodies.
Think of monoclonal antibodies as highly specialized guided missiles for your immune system. They are engineered to hunt down and attach to one specific target—like a protein found only on the surface of a cancer cell—leaving healthy cells alone.
This incredible precision is their superpower. By hitting only the source of the problem, biopharmaceuticals usually cause far fewer side effects than traditional chemotherapy, which kills any rapidly dividing cell it finds, healthy or not. Today, they’re a go-to treatment for many cancers and autoimmune disorders like rheumatoid arthritis and Crohn’s disease.
Gene Therapy Curing The Incurable
Perhaps the most mind-blowing frontier in medical biotech is gene therapy. This approach aims to treat or cure diseases by going straight to the source: the faulty gene itself. It works by introducing new genetic material into a patient’s cells to either fix a broken gene or give the cells a new, helpful ability.
What was once pure science fiction is now clinical reality.
- Correcting Genetic Disorders: We now have approved gene therapies that can treat inherited conditions like spinal muscular atrophy (SMA) and certain types of blindness. They work by delivering a working copy of the gene that was missing or broken.
- Arming The Immune System: In a revolutionary cancer treatment called CAR-T cell therapy, a patient’s own immune cells are taken out, genetically reprogrammed in a lab to hunt their specific cancer, and then put back into their body to do the job.
These therapies aren’t just about managing symptoms anymore. They represent a monumental shift toward offering potential one-time cures for diseases once considered a life sentence. In this field, the use of tiny biological machines is a fascinating area of development. If you’re curious, you can learn more in our guide on nanotechnology applications in medicine.
Biotechnology isn’t just adding a few new gadgets to the doctor’s toolkit; it’s completely rewriting the rules of what’s possible, making medicine more precise, personal, and potent than ever before.
Navigating The Ethical Questions And Future Challenges
Once we started tinkering with the basic code of life, it was inevitable that we’d also open up a Pandora’s box of ethical questions. The incredible power of biotechnology isn’t just about creating amazing solutions; it forces us to have some tough conversations about how we should use it responsibly.
This isn’t about hitting the brakes on innovation out of fear. It’s about being smart and steering this technology with some foresight, making sure it actually benefits everyone in a fair and just way. Let’s get into some of the biggest ethical debates that are defining what biotech will mean for our world.
The Debate Around Gene Editing In Humans
Perhaps no topic gets people more fired up than the idea of gene editing human embryos. Tools like CRISPR, which let us edit DNA with incredible accuracy, have thrown open doors to possibilities that used to be pure science fiction. On one hand, this could mean completely wiping out devastating genetic diseases like Huntington’s or cystic fibrosis before a baby is even born.
But on the other hand, it brings up the whole “designer babies” nightmare—a scenario where parents could pick and choose traits like height, intelligence, or athletic skill. That’s a very slippery slope that could create a new kind of social divide, where only the rich can afford to give their kids a genetic leg up. The real question isn’t just can we do it, but should we?
The core ethical dilemma is drawing a line between therapy and enhancement. Where does treating disease end and creating a genetically stratified society begin? This is a boundary that society, not just scientists, must define.
Genetic Privacy In A Data-Driven World
As DNA sequencing gets cheaper and more common, our genetic code is just becoming another piece of personal data. Companies are happy to trace your family tree or guess your health risks from a bit of saliva. While that can be fascinating, it also creates some serious privacy headaches.
Who actually owns your genetic data? How is it being stored and who is it being shared with? A person’s genome holds some of the most personal information possible, not just about them but their entire family. The risk of this data being used against people—by insurance companies, employers, or other groups—is a real threat that needs strong legal protection.
Environmental Impact Of GMOs
The conversation around genetically modified organisms (GMOs) is another major ethical battleground. Supporters point to some pretty clear wins: crops engineered to fight off pests can cut down on the need for chemical pesticides, and plants designed to survive droughts can help keep food on the table as our climate changes.
However, critics bring up valid points about the long-term effects on the environment. There are worries that GMOs could cross-pollinate with wild plants, which could throw entire ecosystems out of whack. We have to make sure the upsides of agricultural biotech don’t come with a hidden ecological price tag, and that requires constant research and open regulation. For a deeper understanding of the specific editing techniques involved, you might be interested in our guide that explains how CRISPR works.
Tackling these challenges means we need a global agreement on ethical rules and solid oversight. This is the only way to ensure that the incredible promise of biotechnology leads to a future that is safe, fair, and responsible for everyone.
The Future Of Biotechnology And Global Trends
If you think biotech is moving fast now, you haven’t seen anything yet. The tools and techniques we have today are setting the stage for breakthroughs that could fundamentally change medicine, how we make things, and even our understanding of life itself. Looking down the road, a few key trends are clearly taking the lead, pushing the limits of what we thought was possible.
One of the most mind-bending areas is Synthetic Biology. Think of it as the next evolution of genetic engineering. Instead of just snipping and moving existing genes around, synthetic biologists are actually designing and building biological parts and systems from the ground up. The goal is to create organisms that can do things nature never intended, like bacteria that can be programmed to produce complex drugs or to hunt down pollutants in the environment.
The Power Of AI And Bioinformatics
Another massive force is the merger of artificial intelligence (AI) and bioinformatics. Modern biology, especially with DNA sequencing and cellular analysis, produces an unbelievable amount of data. AI algorithms are proving to be exceptionally good at digging through these mountains of information to find patterns that would be completely invisible to the human eye.
This partnership is putting drug discovery into overdrive. AI can predict how a potential drug molecule might behave inside the body, which drastically cuts down on research time and development costs. It’s also pushing personalized medicine from a futuristic concept to a present-day reality, helping doctors analyze a patient’s unique genetic code to pinpoint the most effective treatment.
The future of biotech isn’t just about what we can do in the lab; it’s about how quickly and intelligently we can analyze the results. AI is the engine that will drive discovery at an unprecedented scale.
A Shifting Global Landscape
The geography of biotech innovation is also getting a major shake-up. While North America and Europe have long been the traditional leaders, the Asia-Pacific region is quickly rising to become a global force. Biotechnology in this region was valued at USD 372.23 billion in 2024 and is on track to hit a staggering USD 1,611.67 billion by 2034.
This growth is largely powered by countries like China and India, where huge government investments are pouring into research and development. This isn’t just an economic story; it means more brilliant minds from more parts of the world are now tackling global health and environmental crises. You can dive deeper into the numbers by reviewing the latest analysis of the biotechnology market.
Some of the applications on the horizon sound like they’re ripped from the pages of a sci-fi novel, but they are closer than you might think:
- Nano-robots designed to navigate our bloodstream and deliver medicine directly to cancer cells.
- Lab-grown meat and other cellular agriculture products that provide a sustainable alternative to traditional farming.
- Living biosensors that can exist inside our bodies to continuously monitor our health.
These are just a few glimpses into a future where biotechnology will play an even more integral role in our day-to-day lives.
Frequently Asked Questions About Biotechnology
As you start to explore biotechnology, a few common questions always seem to pop up. Let’s clear the air and tackle some of the big ones to help solidify your understanding.
Is Biotechnology The Same As Genetic Engineering?
This is a distinction that trips a lot of people up. The short answer is no, but they’re definitely related.
A good way to think about it is that biotechnology is the entire workshop, while genetic engineering is one of the most sophisticated power tools on the workbench.
- Biotechnology is the broad, overarching field. It’s about using living systems or their parts to create products or solve problems. This includes everything from ancient fermentation (think bread and beer) to the most advanced modern science.
- Genetic engineering is a specific, powerful technique within biotechnology. It involves directly manipulating an organism’s DNA to change its characteristics.
So, making yogurt is a classic example of biotechnology, but it doesn’t involve any genetic engineering. On the other hand, creating insulin with modified bacteria is genetic engineering, and therefore also falls under the larger umbrella of biotechnology.
In short: Biotechnology is the “what”—the overall practice of using biology for technology. Genetic engineering is one of the most important “hows”—a method for getting it done.
What Do You Study To Work In Biotechnology?
Because the field is so interdisciplinary, several different educational paths can get you into a biotech career. It all starts with a solid foundation in the sciences, usually a bachelor’s degree in a related major.
Some of the most common degrees for aspiring biotech professionals include:
- Biotechnology or Bioengineering
- Molecular and Cellular Biology
- Genetics or Genomics
- Biochemistry or Chemistry
- Microbiology
For roles that are heavy on research and development (R&D), you’ll almost certainly need an advanced degree like a Master’s or a Ph.D. These programs let you specialize in specific areas like bioinformatics or gene therapy. If you’re more interested in hands-on lab work, a position like a biological technician is a great way to enter the industry with just a bachelor’s degree.
Are Biotechnology Products Safe?
Safety isn’t just a concern; it’s the absolute top priority. Every single product that comes out of a biotech lab—whether it’s a medicine, a food crop, or an industrial chemical—goes through an incredibly rigorous gauntlet of testing and regulatory approval before it ever reaches the public.
In the United States, multiple government bodies, including the Food and Drug Administration (FDA), the Environmental Protection Agency (EPA), and the Department of Agriculture (USDA), are involved in oversight. They are tasked with evaluating every new product for any potential risk to human health or the environment.
This intense process is what ensures that genetically modified foods are safe to eat and that new medical treatments are not only effective but also have a risk-to-benefit profile that makes sense for patients.
At maxijournal.com, we are dedicated to bringing you clear and engaging stories from the frontiers of science and technology. To keep exploring fascinating topics, check out our latest articles at https://maxijournal.com.
Discover more from Maxi Journal
Subscribe to get the latest posts sent to your email.


